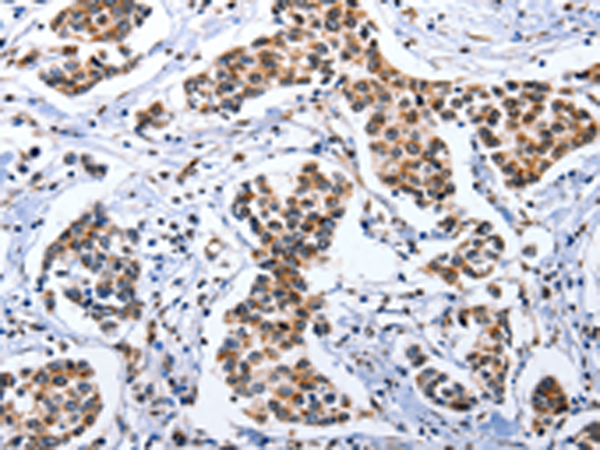

|
Background: |
DOK3 gene maps to chromosome 5q35.3. Dok3 was tyrosine phosphorylated by Src family members Lck, Fyn, and Lyn. Immunoprecipitation studies showed that Dok3 bound inhibitors SHIP and Csk but did not bind RasGAP. Dok3 binding to SHIP occurred via the SH2 domain. Dok3 also bound Csk via the Csk SH2 domain with possible involvement of the Csk SH3 domain as well.DOK proteins are enzymatically inert adaptor or scaffolding proteins. They provide a docking platform for the assembly of multimolecular signaling complexes. DOK3 is a negative regulator of JNK signaling in B-cells through interaction with INPP5D/SHIP1. May modulate ABL1 function |
|
Applications: |
ELISA, WB, IHC |
|
Name of antibody: |
DOK3 |
|
Immunogen: |
Fusion protein of human DOK3 |
|
Full name: |
docking protein 3 |
|
Synonyms: |
DOKL |
|
SwissProt: |
Q7L591 |
|
ELISA Recommended dilution: |
1000-5000 |
|
IHC positive control: |
Human breast cancer |
|
IHC Recommend dilution: |
10-50 |
|
WB Predicted band size: |
53 kDa |
|
WB Positive control: |
Human notum skin cancer tissue |
|
WB Recommended dilution: |
500-2000 |
購(gòu)物車
幫助
021-54845833/15800441009
